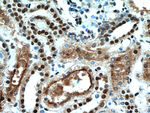
SET Antibody in Immunohistochemistry (Paraffin) (IHC (P))

Search
Proteintech
SET Polyclonal Antibody
{{$productOrderCtrl.translations['antibody.pdp.commerceCard.promotion.promotions']}}
{{$productOrderCtrl.translations['antibody.pdp.commerceCard.promotion.viewpromo']}}
{{$productOrderCtrl.translations['antibody.pdp.commerceCard.promotion.promocode']}}: {{promo.promoCode}} {{promo.promoTitle}} {{promo.promoDescription}}. {{$productOrderCtrl.translations['antibody.pdp.commerceCard.promotion.learnmore']}}
产品信息
55201-1-AP
种属反应
已发表种属
宿主/亚型
分类
类型
抗原
偶联物
形式
浓度
规格
纯化类型
保存液
内含物
保存条件
运输条件
产品详细信息
This antibody is specific to SET. It can recognize isoform1 and isoform2 of SET.
靶标信息
SET is a multitasking protein, involved in apoptosis, transcription, nucleosome assembly and histone binding. Isoform 2 anti-apoptotic activity is mediated by inhibition of the GZMA-activated DNase, NME1.
仅用于科研。不用于诊断过程。未经明确授权不得转售。
生物信息学
蛋白别名: chromatin remodelling factor; HLA-DR-associated protein II; I IGAAD; I-2PP2A; I2PP2A; IGAAD; Inhibitor of granzyme A-activated DNase; inhibitor-2 of protein phosphatase-2A; OTTHUMP00000022286; PHAPII; Phosphatase 2A inhibitor I2PP2A; protein phosphatase type 2A inhibitor; Protein SET; RP11-216B9.3; SET; SET nuclear oncogene; SET translocation (myeloid leukemia-associated); TAF-1a; TAF-1b; TAF-I; TAF1; I2PP2A; Template-activating factor I; Template-Activating Factor-I, chromatin remodelling factor; unnamed protein product
基因别名: 2PP2A; I2PP2A; IGAAD; IPP2A2; MRD58; PHAPII; SET; TAF-I; TAF-IBETA
UniProt ID: (Human) Q01105
Entrez Gene ID: (Human) 6418